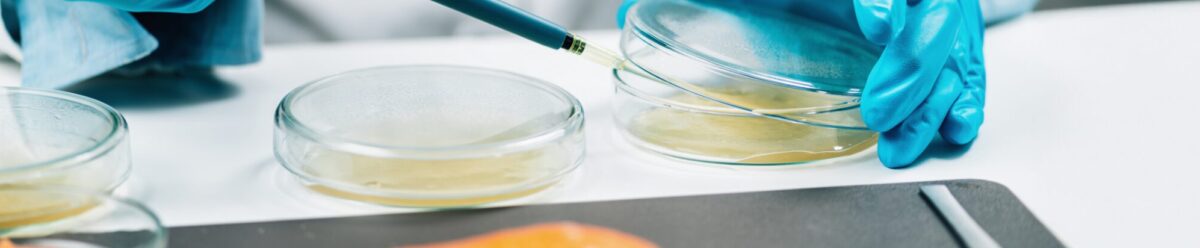
Wissenschaftler mit Pipette untersucht Proben in Petrischalen, Symbol für Qualitätskontrolle, Produktsicherheit und die Absicherung durch eine Rückrufkostenversicherung.

Versicherung für Hersteller und HandelsbetriebeDie Rückrufkostenversicherung
Ein Produkt ist fehlerhaft oder birgt potenzielle Gefahren für Verbraucher? In solchen Fällen kann ein Rückruf unumgänglich sein – und mit erheblichen Kosten verbunden sein. MRH Trowe unterstützt Sie mit fundierter Beratung und der Vermittlung einer geeigneten Rückrufkostenversicherung.
Die Versicherung übernimmt typische Rückrufkosten wie Transport, Lagerung, Entsorgung, Kommunikation und eventuelle Ersatzmaßnahmen. Besonders für Hersteller und Händler ist diese Absicherung essenziell, um wirtschaftliche Risiken und Reputationsverluste im Ernstfall zu minimieren.
Für wen ist die Rückrufkostenversicherung sinnvoll?
- Hersteller und Produzenten
- Handels- und Vertriebsunternehmen
- Unternehmen mit sicherheitsrelevanten oder verbrauchernahen Produkten